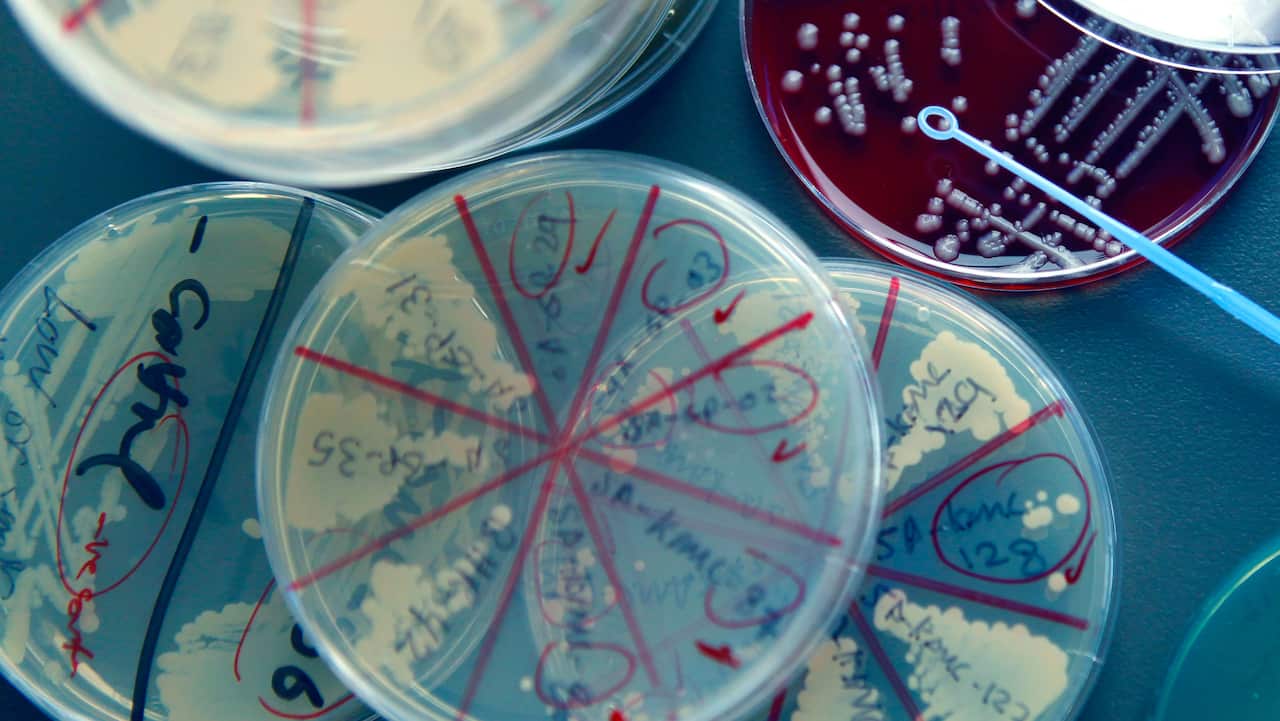
Petri dishes containing a multitude of Super Bugs inside the UQ Paterson Lab

بكتيريا مقاومة للمضادات الحيوية تغزو دول مجلس التعاون الخليجي، والباحثون يحذرون من العدوى منها أثناء السفر ونقلها الى استراليا ودول أخرى في العالم.
توصل باحثون من جامعة كوينزلاند إلى أن دول الخليج العربي في الشرق الأوسط تشهد نموّاً سريعاً لموجة جديدة من الجراثيم الخارقة المقاومة للمضادات الحيوية لم تشهدها المنطقة من قبل.
وقال الدكتور حسام زواوي، رئيس مجموعة الأبحاث في جامعة كوينزلاند، إن السلالات الجديدة المقاومة للمضادات الحيوية تشكل "تهديدا عالميا" وتعيد البشر الى مرحلة ما قبل اكتشاف المضادات الحيوية لعلاج الامراض المختلفة.
ويتضمن هذا البحث شبكة مكوّنة من مستشفيات وباحثين من جميع أنحاء العالم.
وجامعة كوينزلاد هي قائدة هذا البحث العالمي، اذ تُرسل لها أغلبية العينات ليتم تحليلها في معمل الدكتور حسام زواوي، والكشف ما اذا كانت هذه البكتيريا مقاومة للمضادات الحيوية، ودراسة التركيبات الجينية لها.
وتشير نتائج بحث جامعة كوينزلاند الجديد إلى أن منطقة الخليج قد تحتوي أيضًا على سلالات فريدة من نوعها تنتشر وتهيمن على دول الخليج.
وعن احتمالية انتشارها في استراليا، يقول الدكتور زواوي انها قد تنتشر من خلال السفر الى هذه المناطق ان لم يتخذ المسافر الاحتياطات اللازمة و أولها "غسل اليدين بشكل مستمر".
"السفر الدولي هو أحد أسباب انتشار الامراض المعدية بشكل عام. وهذا يتضمن نقل بكتيريا المقاومة للمضادات الحيوية،" يقول دكتور زواوي.
وكانت قد نشرت جامعة كوينزلاند والجامعة الوطنية الاسترالية بحثا يثبت بان الاستراليين ينقلون هذه البكتيريا الى استراليا من خلال جهازهم الهضمي وتمكث فيه لفترة زمنية.
"الحكومة الاسترالية وافقت على أخذ الخطوات الهامة في مقاومة البكتيريا المقاومة للمضادات الحيوية وصممت خطة وطنية لمكافحة هذه البكتيريا كغيرها من الدول الأخرى.
ويذكر الدكتور زواوي أن الانتشار المتزايد لهذه الجراثيم عالية الخطورة، هو أمر مثير للقلق لأنه يمكن أن يكون من الصعب جدا علاجه، ويمكن أن يؤدي إلى الوفاة عند المرضى الذين يعانون من نقص المناعة أو أولئك الذين يمكثون في وحدة العناية المركزة في المستشفيات.
"كنا نعلم أن هذه الجراثيم يمكن أن تنمو داخل المستشفيات وتنتقل من مريض إلى آخر، ولكن هذه المرة الأولى التي نكتشف فيها انتشارها في شبه الجزيرة العربية بأكملها".
ويأمل الأستاذ الدكتور ديفيد باترسون، مدير مركز البحوث السريرية في جامعة كوينزلاند ، أن تُؤخذ هذه الدراسة الدولية بعين الاعتبار، مما سيؤدي إلى تحسين إجراءات مكافحة العدوى واستخدام المضادات الحيوية بشكل أفضل.
الدكتور زواوي يقول إن ترشيد استخدام المضادات الحيوية في وقت الحاجة فقط، واتباع بروتوكولات مكافحة العدوى ونشرالوعي حول الوسائل المستخدمة لمكافحة البكتيريا الخارقة سيساعد في السيطرة على انتشارها.
نتائج هذه الأبحاث تم نشرها في مجلة علم الأحياء الدقيقة الطبية.
وللاستماع الى اللقاء الكامل مع الدكتور حسام زواوي، يمكنكم الضغط على أيقونة تشغيل المرفق الصوتي أعلاه.
استمعوا هنا الى البث المباشر لاذاعتنا و لاذاعة BBC أيضا
حمّل تطبيق أس بي أس الجديد على الأندرويد والآيفون للإستماع لبرامجكم المفضلة باللغة العربية.


